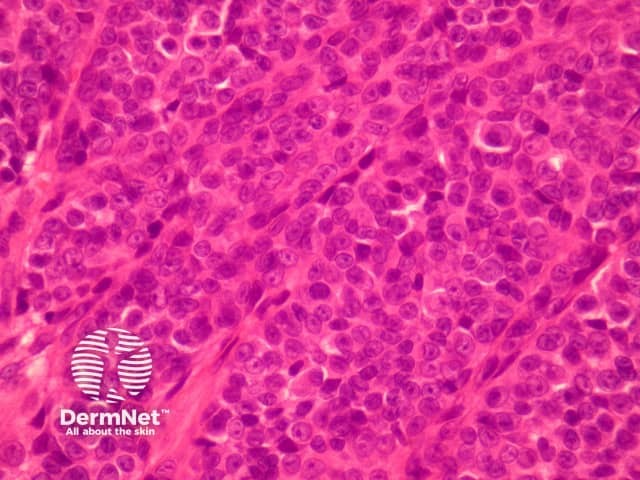
Figure 4

Main menu
Common skin conditions
NEWS
Join DermNet PRO
Read more
Quick links
Lesions (cancerous) Diagnosis and testing
Author: A/Prof Patrick Emanuel, Dermatopathologist, Auckland, New Zealand, 2014.
Introduction
Histology
Special studies
Differential diagnoses
Melanoma in childhood is fortunately rare but often presents at a late clinical stage due to delays in biopsy and diagnosis. Predisposing factors are thought to be similar to adult melanoma.
Childhood melanoma may occur within a giant congenital naevus or can present as Spitzoid, nodular or superficially spreading types of melanoma.
The case illustrated here shows a nodular melanoma arising on the arm of an 8-year-old boy (figures 1-5). This tumour shows ulceration, lack of dermal maturation, dermal mitoses, pagetoid invasion of the epidermis and nuclear pleomorphism.

Figure 1

Figure 2

Figure 3
Figure 4

Figure 5
Given the reluctance of making this diagnosis in children, ancillary studies such as fluorescent in situ hybridisation (FISH) and CGH can be helpful in increasing diagnostic confidence. FISH was performed on the case illustrated herein and showed numerous abnormalities, as would be expected for melanoma.
Immunohistochemical studies may be helpful to illustrate high proliferative rates (Ki-67), and pagetoid invasion (Melan-A).

Childhood melanoma FISH pathology
Abnormal FISH shows RREB1 (6p25; red probe) Gain; MYB (6q23, yellow) Loss
Spitz naevus – Difficult cases may need external consultation and cytogenetic analysis.
Proliferative nodules within congenital naevi – Difficult cases may need external consultation and cytogenetic analysis.